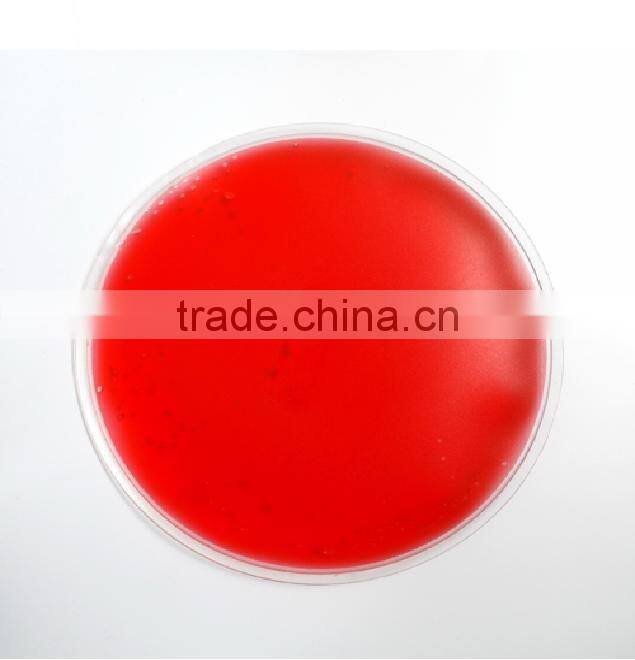
Round Reusable Ice pack, gel bead cold pack, gel beads ice pack

Round Reusable Ice Pack, Gel Bead Cold Pack, Gel Beads Ice Pack
size:10*10cm
material: PVC
opp bag
120pcs/ctn31.5*21.5*20cm
g.w./n.w.:8.0/9.0kgs
opp bag
120pcs/ctn31.5*21.5*20cm
g.w./n.w.:8.0/9.0kgs
We set up a strong after sale service team, for different professional customer we will tracking, maintenance, and establish the full-time personnel reception to deal with customers’ complaints, listen to the views of customers fully, and improve the product quality constantly.
Company Information
Our company do international trade is more than 14 years, specialized in general merchandise and located in Ningbo, also we have office in Ningbo. There are total 5000m2 showroom in Ningbo and Yiwu, more than 30 000 items for our choice. Our items include: household, hardware, kitchenware, bathroom item, stationery item, gift item, make up item, etc
Send Inquiry to This Supplier
You May Also Like
-
Custom Reusable Gel Ice Packs Hot & Cold Health Care Product With Personalized LogoNegotiableMOQ: 10000 Packs
-
Smart Incontinence Care Robot for HomecareUS$ 3850 - 4650MOQ: 1 Piece
-
Hydrogel Pads Abdominal Gel Fitness Equipment Machine Stickers BlueNegotiableMOQ: 1
-
Shock Price Digital of Therapy of Machine of Massager Instruction on With LCD ScreenUS$ 6 - 8MOQ: 100 Pieces
-
The Whole Network Lowest Top Quality Types of Vascular BirthmarksUS$ 1 - 500MOQ: 1 Piece
-
Magical Treatment Effect Home Use Fleck Removal and Nevus Removal PenUS$ 1 - 99MOQ: 1 Piece
-
2016 Europe Star! Freeze Sculptor Machine/ Cryolipolysie Cellulite Reduction Fat Freezing Cellulite Reduction Machine Improve Blood CirculationUS$ 3,000 - 7,000MOQ: 1 Unit
-
Wooden Foot Massager With Plastic WheelUS$ 0.3 - 1.5MOQ: 2000 Pieces
-
Body Wooden Massager for Wooden CraftsUS$ 0.25 - 3MOQ: 1000 Pieces
-
Sunmas Office Electric Stimulator ReviewUS$ 1 - 20MOQ: 100 Pieces